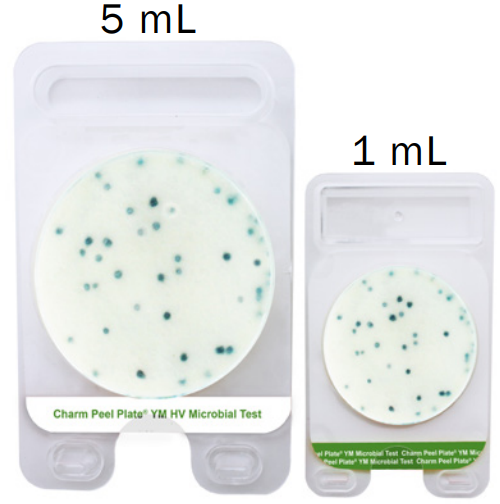
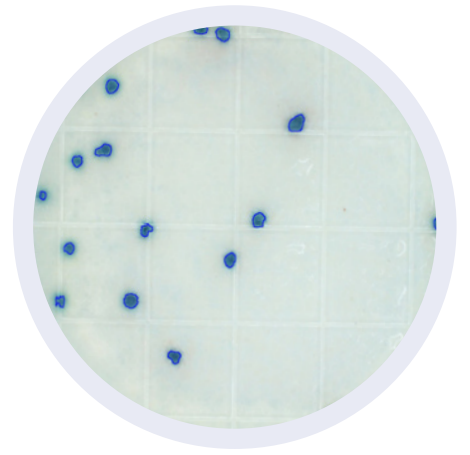

La placa Peel Plate YM HV está basada en el agar convencional de dextrosa de patata (PDA) combinada con agentes selectivos para cultivar e identificar colorimétricamente el crecimiento de levaduras y mohos. Contiene sustratos enzimáticos que se colorean azul cuando detectan las enzimas fosfatasa y glucuronidasa producidas por el crecimiento de hongos.
Beneficios
- Peel Plate YM HV ha sido validado para la detección de levaduras y mohos en productos lácteos (líquidos, sólidos y cultivados), jugos y extractos de panadería, además de también contar con certificaciones para detectar hongos de esponjas ambientales provenientes de superficies en contacto con alimentos.
- Cuenta con cuadrículas grabadas para recuentos estimados.
- Vida útil de hasta 12 meses a temperatura ambiente o en refrigeración cuenta con una bolsa de aluminio con cierre hermético “zip”.

- Rendimiento robusto con buffers neutralizantes utilizados en muestras de superficies ambientales.
- Simplemente agregue la muestra / dilución. No se necesita de accesorios para difundir la muestra (difusor).
- Las colonias se recogen fácilmente para posterior aislamiento /clasificación.
Procedimiento
1

Levante
2

Pipetee verticalmente
3

Selle
Charm Peel Plate
Las pruebas Charm Peel Plate son placas microbianas de métodos de cultivo simplificados para la detección de microorganismos, cuentan con la certificación de la AOAC-RI en donde se garantiza el desempeño de las pruebas AC (Aerobios), EC (E-coli coliformes), YM (Mohos y Levaduras). Asi como también la prueba EB, (Enterobacterias), recibió la certificación MicroVal armonizada con la AOAC en “The Official Method of Analysis First Action Status”.
Para alimentos lácteos las pruebas Charm Peel Plate AC (Aerobios), CC (Coliformes), EC (E-coli coliformes) y Cultured dairy CC y EC cuentan con la aprobación FDA/NCIMS.

Las pruebas de Peel Plate se utilizan en productos lácteos, carnes molidas, otros alimentos, superficies ambientales de contacto y agua. Peel Plate cuenta con pruebas de 1 ml de volumen, para bacterias aeróbicas (prueba Peel Plate AC), recuento heterotrófico (prueba Peel Plate HET) y Staphylococcus Aureus (prueba Peel Plate SA). También cuenta con pruebas de 1 ml y 5 ml (High Volume) para el recuento de coliformes (prueba Peel Plate CC), coliformes / E. coli (prueba Peel Plate EC), enterobacteriaceae (prueba Peel Plate EB) y levaduras y mohos (prueba Peel Plate YM
